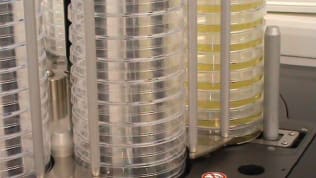
Feature Image

Stories
35
63
61
0
1050
30
INSIDER Product: Imaging
Fastec Imaging’s (San Diego, CA) IL5 High-Speed 5MP Camera enables you to record production lines moving at high speed for analysis or troubleshooting using slow motion replay. There are four models to choose from, boasting...
INSIDER Product: Imaging
Sierra-Olympic Technologies (Hood River, OR) recently introduced the Viento 67-640 thermal camera for perimeter surveillance, robotics, and other rugged outdoor imaging applications. The new thermal imager features a fixed...
Articles: Imaging
Cameras are the eyes of the modern world. The devices equip today’s cars and machines, and real-time imaging capabilities support law enforcement, businesses, and homeowners. Thus far, cameras have been just that:...
Articles: Photonics/Optics
Scientific laser users have long relied on state-of-the-art performance (e.g., higher peak power, shorter pulse duration, wider wavelength tuning) to achieve groundbreaking results....
Products: Photonics/Optics
SMARTEK Vision (New London, CT) offers the “twenty-nine” series of CMOS machine-vision cameras. Distributed by FRAMOS Technologies (Ottawa, Ontario, Canada), the 29 x 29- mm camera line fits GigE Vision and USB3 Vision with a...
Application Briefs: Photonics/Optics
A University of Florida Institute of Food and Agricultural Sciences researcher has developed a machine vision system to measure the quantity of a citrus grove’s dropped and...
Products: Photonics/Optics
The T1030sc thermal imaging camera from FLIR Systems (Wilsonville, OR) features hardware, software, and a 1024 × 768 HD-IR detector. High-fidelity images are created using FLIR’s OSX™ Precision HDIR optics, which include an...
Products: Photonics/Optics
Precision Glass & Optics (PG&O) (Santa Ana, CA) announced the customization of two thin-film optical components for a high-field magnetic resonance imaging (MRI) accessory developed by Avotec, Inc....
Products: Manufacturing & Prototyping
A new generation of industrial picosecond lasers from Coherent, Inc. (Santa Clara, CA) combines high-performance and exceptional reliability in a lower-cost platform to make a wide range of precision materials...
Products: Photonics/Optics
Precision motion and nanopositioning systems specialist PI (Physik Instrumente) L.P. (Auburn, MA) recently released the smallest member in their miniature rotary stage series with ultrasonic piezo motor drives....
Products: Photonics/Optics
The FireBird Camera Link Deca board frame grabber from Active Silicon (Iver, UK) is now available in two form factors: a full-height version with front panel IO and a low-profile/half-height version. The low-profile design allows...
Products: Imaging
A new series of low-cost DC drive motors from Siskiyou Corporation (Grants Pass, OR) enables precise, hands-free adjustment of translation stages and mirror mounts, using a simple, push-button control pad. Specifically, the...
INSIDER: Photonics/Optics
Cellular biologists work at a frustratingly small scale. Like their colleagues in particle physics, these scientists investigate fundamental questions about our lives and our world —...
INSIDER: Materials
A pair of University of Alabama in Huntsville (UAH) researchers aim to explore fundamental properties of infrasonic optical sensors that could make them more sensitive...
INSIDER: Energy
A novel three-dimensional solar cell design developed at Georgia Tech will soon get its first testing in space aboard the International Space Station. An experimental module containing 18...
INSIDER Product: Test & Measurement
Elma Electronic Inc. (Fremont, CA) now offers a rugged, high performance embedded vision system that incorporates four configurable Camera Link ports and a front-removable, multi-terabyte storage bay with SATA III...
INSIDER Product: Photonics/Optics
Andor Technology (Belfast, Northern Ireland) has announced the launch of Dragonfly, a high-speed confocal imaging platform supporting multiple high-contrast imaging techniques. Dragonfly integrates Andor’s cameras with...
INSIDER Product: Imaging
The D200 is the latest in Highland Technology's (San Francisco, CA) line of high-performance compact precision laser drivers. A DC-coupled trigger signal produces fast, 2 nanosecond transitions. Up to 4 amps of regulated drive...
INSIDER Product: Photonics/Optics
Fiber Optic Center, Inc., (FOC) (New Bedford, MA) has announced the addition of the FiberChek Probe from Viavi to focenter.com. Meeting all fiber inspection needs with built-in image viewing, auto-focus, pass/fail...
Articles: Imaging
The Near-Earth Object Camera (NEOCam) is part of a proposed NASA mission to find potentially hazardous asteroids. In a Q&A with Photonics & Imaging Technology, NEOCam principal...
Articles: Manufacturing & Prototyping
High-definition digital projectors based on Texas Instruments’ DLP® technology are widely known for being used in more than 90% of the world’s digital movie theaters. However, DLP chips...
Articles: Imaging
Thanks to a combination of high-quality optics and advanced digital imaging technology, today’s newest digital microscopes provide efficient solutions to a...
Application Briefs: Photonics/Optics
The “always-true” use case for 360º vision systems is to avoid blind spots. Blind spots are a byproduct of conventional cameras. They have a limited field of view and they only see in the direction...
Briefs: Photonics/Optics
Smartphone Video Guidance Sensor
The need arose to apply the state determination algorithms developed for the Advanced Video Guidance Sensor autonomous rendezvous and docking (AR&D) sensor onto a commercial off-the-shelf (COTS), smartphone-based platform to create a lower-mass, lower-cost sensor for small satellite and CubeSat applications....
Briefs: Photonics/Optics
A Smooth-Walled Feedhorn with Sub-30-dB Cross-Polarization Over a 30-Percent Bandwidth
The focus of this research was the design, optimization, and measurement of a monotonically profiled, smooth-walled scalar feedhorn with a diffraction-limited ~14° FWHM (full width at half maximum). It is an easier-to-manufacture, smooth-walled feed that...
Briefs: Imaging
Partially Transparent Circular Mask to Suppress Narrowband Laser Light
The evolved Laser Interferometry Space Antenna (eLISA) is the implementation of the original Laser Interferometry Space Antenna (LISA) concept that will be proposed for the European Space Agency’s (ESA) L.3 Cosmic Visions opportunity. The eLISA observatory uses lasers to range...
Briefs: Photonics/Optics
Characterizing Richness of Previously Unmapped Terrain and Estimating its Impact on Navigation Performance using 3D Range Sensors in Flight
Landers to large planetary bodies such as Mars typically use a secondary reconnaissance spacecraft to generate high-fidelity 3D terrain maps that are subsequently used for landing site selection and creating...
Briefs: Imaging
Measurements of the cosmic micro wave background are a powerful probe of the early universe. Part-per-million fluctuations in the intensity of background trace the initial...
Briefs: Photonics/Optics
A Novel Orbiting Cloud Imager System for IR/UV/X-Ray Bands
Typically, the cost of a spaceborne imaging system is driven by the size and mass of the primary aperture. Innovative solutions for imagers that are less complex and are lightweight are very desirable. Currently, telescopes such as JWST and ATLAST are very expensive and very complex.
Top Stories
Blog: Lighting
A Stretchable OLED that Can Maintain Most of Its Luminescence
INSIDER: Energy
Advancing All-Solid-State Batteries
Blog: Energy
Batteries that Can Withstand the Cold
Blog: AR/AI
My Opinion: We Need More Power Soon — Is Nuclear the Answer?
Quiz: Power
Blog: Design
Webcasts
 On-Demand Webinars: Transportation
On-Demand Webinars: Transportation
Quiet, Please: NVH Improvement Opportunities in the Early Design Cycle
 Upcoming Webinars: Test & Measurement
Upcoming Webinars: Test & Measurement
From Spreadsheets to Insights: Fast Data Analysis Without Complex...
 Upcoming Webinars: Aerospace
Upcoming Webinars: Aerospace
Cooling a New Generation of Aerospace and Defense Embedded...
 Upcoming Webinars: AR/AI
Upcoming Webinars: AR/AI
Beyond AI-Copy-Paste Engineering: Advanced AI-Integration Success...
 Upcoming Webinars: Energy
Upcoming Webinars: Energy
Battery Abuse Testing: Pushing to Failure